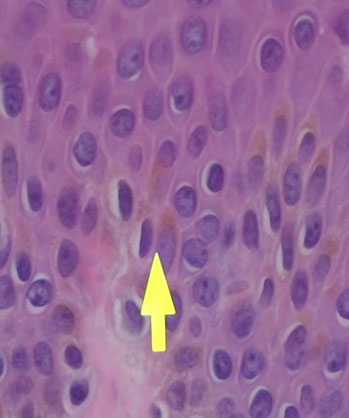
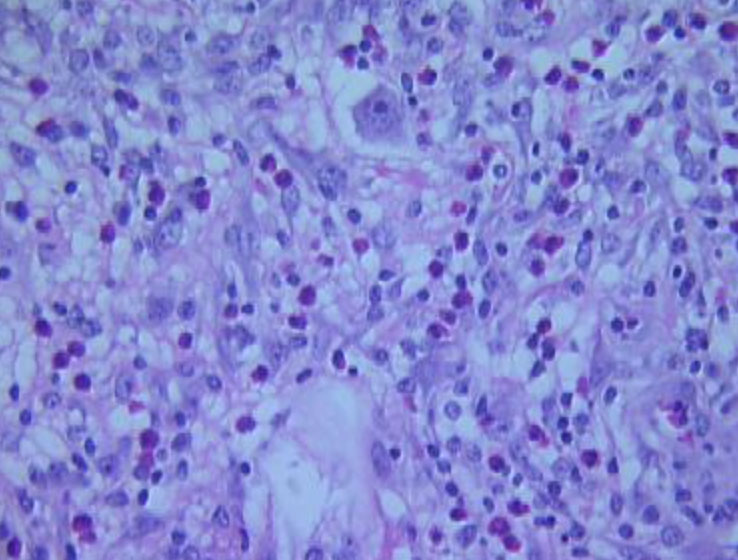
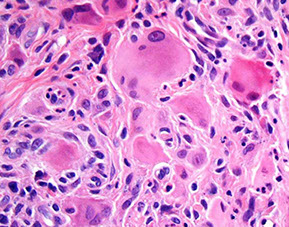

Skin
Derm Anatomy and Common Terms
Infectious Dermatology
Anatomy
- Epidermal layers
- Epithelial cell junctions
- Zona occludens (tight junction)
- Zona adherence (intermdiiate junction)
- Macula adherens (desmosome)
- Gap junction
- Hemidesmosome
- Integrin
Common Terms
Blistering Dermatopathology
Bullous pemphigoid (BP)
Cicatrical pemphigoid
Dermatitis herpetiformis
Familial benign chronic pemphigus (Hailey-Hailey disease)
Keratosis follicularis (Darier's disease)
Pemphigus foliaceus
Pemphigus vulgaris
Porphyria cutanea tarda
Transient acantholytic dermatosis (Grover's disease)
Arthropods
- Scabies
Bacteriae
- Bacillary angiomatosis
- Granuloma inguinale
- Leprosy
- Rhinoscleroma
Viri
- Condyloma acuminatum
- Condyloma latum (secondary syph)
- Cytomegalovirus
- Epidermodysplasia verruciformis (EDV)
- Herpes simplex
- Herpes Zoster
- Molluscum contagiosum
- Varicella
- Viral exanthem
- Verruca plana
- Verruca vulgaris
Fungi / Yeast
- Chromoblastomycosis
- Tinea nigra
- Tinea versicolor
Protothecosis
Genodermatosis, metabolic and other structural disorders
Inflammatory Dermatopathology
Acne
Necrolytic Migratory Erythema
Spongiosis
- Eczema
Psoriasiform (epiderm hyplerplasia)
- Psoriasis
- Seborrheic dermatitis
Interface / Lichenoid
- Erythema multiforme (EM)
- Lichen planus
- Lichen sclerosus et atrophicus
- Lichen simplex chronicus
- Lichen striatus
- Morphea / scleroderma
- Lupus erythematosus
- Pityriasis lichenoides et varioliformis acuta (PLETA)
- Porokeratosis
- Syphilis
Perivascular
- Arthropod bite
Granulomatous Dermatitis
Granulomatosis
- Chondrodermatitis nodularis chronica helica
- Juvenile Xanthogranuloma
- Granuloma Annulare
- Langerhans Cell Histiocytosis (histiocytosis X)
- Necrobiosis lipoidica
- Necrobiotic xanthogranuloma
- Reticulohistiocytosis
- Rheumatoid nodule
- Sarcoidosis
-
Tuberous xanthoma
- Eruptive xanthoma
- Verruciform xanthoma - see Penis
Panniculidities
- Erythema nodosum
- Nodular vasculitis / Erythema Induratum (EI) of Bazin
Vasculitic
- Acute febrile neutrophilic dermatosis (Sweet's syndrome)
- Leukocytoclastic vasculitis (LCV)
- Perniosis / pernio / chilblains
- Tumid lupus erythematosus
- Hydrophilic polymer vasculopathy
Infiltrates
- Drug rash with eosinophilia and systemic symptoms (DRESS) - see Myeloid neoplasms
Chondrodermatitis nodularis chronica helicis
Mastocytosis / urticaria pigmentosa (UP)
Malignant Atrophic Papulosis
Pseudoxanthoma elasticum
Derm Anatomy and Common Terms
Anatomy
"Fingers" that point down are rete ridges, with papillary dermis (pink hyaline) right next to it, and a dermal papilla interlocking with the rete ridges (with little capillaries in them)
- blood vessels in dermal papilla takes away wast products from the epidermis
- all epidermal layers throughout the body do not have vessels within them, but have vessels in the stroma to nourish them with oxygen and provide layer to grow on
Pink bundles of spindle cells, can be:
1) Dense regular connective tissue, dense collagen
2) Nerve
3) Smooth muscle
Epidermal layers
Takes ~28 days for squame to from stem cells in baslis to mature to corneal layer (top layer)
- in psoriasis grows faster, ~7 days
From top to bottom:
Corneal layer (Stratum corneum) - extra barrier against entry into body, dead cells on top, flake off
- acral skin usually has a thick corneal layer (in addition to the lucidum layer)
Stratum Lucidem - hot pink layer beneath the corneum that is only seen on acral skin (the palms and soles), or as protective mech on skin that has been rubbed too much
- below corneum and above granulosum, only seen on the palms and soles and skin that has been rubbed too much
Granular layer (Stratum Granulosum) - when cells from spinosum start to pick up keratohyaline granules (have loracrin and involucrin little purple granules) that help keratinocytes die and lose nucleus to become skeletons in the corneal layer (stratum corneum)
Stratum Spinosum - little spines, desmosomes bwt cells
- due to shrinkage during processing, cells in the spinosum usually have a halo directly around the nucleus (bc their desmosomes are locked into a network) vs melanocytes that have cytoplasm around their nuclei and sometimes a space around the cytoplasm, bc they are not locked in by desmosomes
Keratinocytes usually have pigment on top of their nuclei, in the direction of the corneum, to protect them from the sun
Stratum Basalis - where stem cells reproduce squamous cells, pushed upward; pink bc filled c keratin
*** California Ladies Give Superb Backrubs ***
*** Callus w corneum ***
- Malphigean layer comprised of stratum spinosum and basalis
Melanocytes - Area around nucleus does NOT have a vacuoles (bc is not locked in like cells in the spinosum) but vacuole forms around the outside of the cytoplasm as the cell shrinks during processing
- look gray not brown, bc exports melanin to surrounding cells, which they do with little cell processes
- darker skin people have same number of melanocytes, but make more melanin
The number of melanocytes is the same bwt races, but the number of melanosomes is different
Langerhans cells - related to histiocytes / macrophages, live in mid-level of spinus layer to protect against invading antigens; which can go all the way back to lymph nodes to present the antigens
- can be seen in little blisters when skin exposed to antigen
PSoriasis: inc in stratum Spinosum
*** PS: I dont love you, Psoriasis! ***
- takes only 7 days for skin to mature c psoriasis (vs 28 days normally)
Epithelial cell junctions
Includes:
Zona occludens (tight junction); Zona adherens (intermediate junction);
Macula adherens (desmosome); Gap junction; Hemidesmosome; Integrin; E-cadherin; Actin filaments; Desmoplakin; Keratin; Connexon w central channel
Zona ocludens (tight junction)
prevents diffusion across paracellular space
- composed of claudins, occludins, and JAMs
Zona adherens (intermediate junction)
Surrounds perimeter, just below zona occludens
- cadherins connect to actin (CADherins are CA2+-dependent ADhesion molecules)
Macula adherens (desmosome)
Small, discrete sites of attachment
- cadherins connect to intermediate filaments
Gap junction
allows adjacent cells to communicate for electric and metabolic functions w connexons
Hemidesmosome
connects cell to basement membrane
Integrin
binds laminin in basement membrane
Dermis
Irregular dense connective tissue
- papillary dermis is fine, thin light pink collagen bwt the rete ridge and dermal papilla (c BV)
- reticular dermis if fatter, darker strands of collagen deeper down
Superficial vascular plexus - slightly larger layer of BVs that separates the papillary and reticular dermis
White spaces on slide? is either
1) a vascular space (lymphovasculae channel) if lined by endothelium
2) a glandular / cystic space that is lined by epithelium
3) artifact
- adipocytes have clear space in them bc lipid is dissolved during processing
Vascular endothelium is surrounded by small pericytes
Sebaceous glands - cells have white spaces in it as artifact bc used to have lipid in them
- when these cells break down they are secreted from the hair follicle as sebum (sebaceous secretion, more common in groin and axilla), smell bad from bacterial action
- basaloid cells around the outside of the gland, give rise to mature sebocytes
Hair follicles - connect to surface
- hair shaft is the pink thing in the middle, surrounded by epithelial layer, sebaceous glands drain into hair follicles
- dark blue cells, matricle cells or germinative epithelium, actively dividing, grows quicky, producing hair
- pink hair papilla grows into hair bulb, giving it nourishment
- hair shaft made of dead keratinocytes packed together
- inner root sheath has trichohyaline granules and looks pink
- outer root sheath, made of glycogen-filled cells that look like piano keys
- adventitia is the bright pink layer after outer root sheath
- melanocytes in the roots give hair its pigment (hair color)
Epidermal inclusion cyst comes from the infundibulum, the layer of cells dipping into a hair follicle, thus EICs should really be called follicular cysts
Eccrine gland - eccrine coil makes sweat that coils out and empties through skin by ducts, lined by double layer of cuboidal epithelium
- outer layer is myoepithelial layer that is supposed to have some contractile property
- usually seen at junction of dermis and subcutis (can be surrounded by a little bit of fat)
- salivary glands other place that has a double layer of cuboidal epithelium, and shares many of the same features in ca
- eccrosyringium is part where sweat gland connects to the skin surface in accral skin, there is usually a break in the skin that allows the sweat to leave
Glomus apparatus (glomus body) - in accral skin, may play role intemperature regulation, surrounded by pericytes that have contractile properties that contract and control blood flow
Paccinian corpuscle - in the fat of accral deep dermis, feels deep touch or vibration
Meissner corpuscle - right under the epidermis, detects fine touch, seen in acral skin. Have a predilection for the tips of the fingers
Dense collagen forms a layer of fascia that separates adipose from muscle (collagen is extracellular, pushed out of a cell)
- dense CT is either fascia, ligament or tendon (muscle to bone)
Nail plate also made of dead keratin
- nail bed epithelium lies beneath the nail plate
IHC of normal skin:
All epithelial cells should stain c some type of keratin
- hair follicle and sweat glands also stain with keratins
S100 stains nerve, melanocytes, and Langerhan cells
- S100 also stains some adipocytes
Desmin stains arrector pili muscles, and blood vessels
CD31 stains the central lining of the vessel, the endothelial cells
- CD34 stains the same thing
Sox10 is a nuclear marker, in the nuclei of melanocytes
Hypodermis
Usually just fat cells (adipocyte)
- little fat droplet within the adipocyte nucleus, called the locurn (or nuclear lake), which is always there in adipocyte nuclei, but not always seen
Common Terms
Acantholysis - loss of intercellular cohesion
Acanthosis - epidermal thickening
Asteroid bodies - red stuff in sporotrichosis, sarcoidosis, berrylliosis
Ballon degeneration - a form of apoptosis assoc loss of intercellular edema and edema
Cowdry A - pink globs in the nucleus assoc c herpes
Cowdry B - pink globs in nucleus assoc c adeno- and polioviri
Donovan body - collection of bacterial amastigotes (Leishmania) seen c granuloma inguinale
Dutcher body - pink globs of Ig in cytoplasm and nucleus of plasma cells
Effacement - loss of rete pegs
Granulomatous - forming granuloma-shaped structure
Dyskeratosis: abnormal keratinization below the stratum granulosum
Hyperkeratosis: thickening of the corneal layer c excess keratin
Hypergranulosis: Inc granular layer as a result of repeated rubbing
Interface change - has vacuoles in basal layer (liquefactive change) with Civatte bodies (seen in lichen planus, which are pink blobs, actually dying keratinocytes) and unclear distinction between dermis and epidermis
- lichenoid change is interface changes with heavy lymphocyte infiltrates
Parakeratosis - nuclei persist into stratum corneum;
- usually assoc c loss of granular layer
- not a normal finding, either skin has been irritated, or there is a rash, or assoc c a tumor
Psoriaform - epidermal hyperplasia
Spongiosis - epidermal edema, desmosomes that are stretched out by edema
- characteristic of eczematous dermatitis
Macule: flat discolored area up to 0.5 cm
Pagetoid spread: melanocytes growing upward toward skin surface
- seen in Paget disease of the nipple, Paget disease of the skin, melanoma, and SCC
Patch: flat discolored area >0.5 cm
Papule: elevated lesion up to 0.5 cm
Vesicle: Fluid-filled raised lesion up to 0.5 cm
Bulla: Fluid-filled raised lesion >0.5 cm
Blister: laymans term for vesicle or bulla
Pustule: discrete, pus-filled raised lesion
Wheal: Itchy, transient, elevated lesion c variable blanching and erythema as the result of edema
Scale: Dry, platelike excresence, usually from imperfect cornification
Lichenification: thick, rough skin similar to that on palms and soles, caused by repeat irritation (scratching)
Excoriation: a deep scratch
Oncholysis: separation of nail plate and nail bed


Epidermis, arrow pointing to stratum Lucidem,
Melanocytes - Area around nucleus does NOT have a vacuoles (bc is not locked in by desmosomes like cells in the spinosum) but vacuole forms around the outside of the cytoplasm as the cell shrinks during processing

Langerhans cells - related to histiocytes / macrophages, live in mid-level of spinus layer

Keratinocytes usually have pigment on top of their nuclei, in the direction of the corneum, to protect them from the sun
Arrow to pink papillary dermis, to the left is a rete ridge, to the right, an interlocking dermal papilla

Sweat gland lined by epithelium, with blue, gooey sweat

Smooth muscle of the arrector pili muscle, which attaches to hair follicle to make them stand on end

Neurovascular bundle with arteriole, venule and nerve

Sebaceous gland


Spongiosis
Parakeratosis

A little bit of lymphocytes, around BV is a farily normal finding

Scalp with long anengen hairs with roots that go into subQ fat

Internal elastic lamina is a squiggly line underneath the intima

Eccrine sweat gland (eccrine coil)
Arrow to hair shaft, in a hair follicle


Glomus body


Meissner corpuscle just below epithelium
Paccinian corpuscle, deep skin

Close up of eccrine gland, with 2 layers of epithelial cells

Pagetoid spread in SCC


Lichenification - dark purple and granular, from too much scratching
Interface change with vacuolization (arrow), Civatte bodies (pink blobs)



Leishmania kinetoplasts - ferris wheel sign is organisms around periphery

Blistering Dermatopathology
Vesiculobullous Dermatitis
Characterized by the location of the bulla
SUBCORNEAL
• Staphylococcal scalded skin syndrome
• Bullous Impetigo
• Pemphigus Foliaceus
• Acute generalized exanthematous pustulosis (AGEP; 2/2 drug rxn)
INTRAEPIDERMAL
• Pemphigus Vulgaris
• Hailey-Hailey Disease
• Darier’s Disease
• Grover’s Disease
• Friction Blister
SUBEPIDERMAL
• Additionally classified based on the intensity and composition of
the inflammation within the bulla:
– Paci-inflammatory
• Epidermolysis Bullosa Aquisita
• Porphyria Cutanea Tarda
• Bullous Pemphigoid (cell-poor variant)
• Suction blisters/burns/blisters over scars
– With Eosinophils
• Bullous Pemphigoid
• Epidermolysis Bullosa Aquisita (inflammatory variant)
– With Neutrophils
• Dermatitis Herpetiformis
• Linear IgA Bullous Dermatosis
• Bullous Lupus
• Cicatricial Pemphigoid
• Epidermolysis Bullosa Aquisita (inflammatory variant)

Staphylococcal scalded-skin syndrome (SSSS). A, Perioral crusting/fissuring and involvement of the folds of the neck are predominant features. This patient also had shallow erosions on the forehead (inset). B, The superficial nature of the split in SSSS (in comparison with Stevens-Johnson syndrome) is evidenced by the superficial, subcorneal erosions. Note how the erosions show a strong predilection for the skin folds as well as
sites of local trauma. C, Blister formation is due to a split at the level of the stratum granulosum, which causes the stratum corneum to detach from the rest of the epidermis. There is no inflammation and no bacteria are seen (this is a toxin-mediated process). D, In some cases, the stratum corneum entirely detaches and may either be lost during processing or found elsewhere on the slide. (Dermatologic Urgencies and Emergencies—Abate et al; Arch Pathol Lab Med—Vol 143, August 2019)
Bullous Pemphigoid (BP)
Pruritic, blistering autoimmune skin disorder c IgG abs to hemidesmosomes (BPAg1 and BPAg2)
- forms tense blisters on the extremities and trunks of older pts
- less severe than pemphigus vulgaris
*** "Pemphigoid" is longer than "pemphigus", "Hemidesmostome" is longer than "Desmosome" ***
Micro: Subepidermal blister (bullae) c eos and sometimes neutros in blister cavity
- can see eos lined up on DE junction in urticarial lesions
IF: Direct IF in perilesional tissue shows IgG and C3 on DE junction (basement membrane) in linear or n-serrated pattern
- Indirect has positivity on the roof of the lesion (vs on the floor in epidermolysis bullosa acquisita)

Bullous pemphigoid


Bullous pemphigoid
Cicatrical pemphigoid
Tense bullae that heal c scarring that occur in oral and ocular mucosa
Micro: subepidermal vesiculation c variable inflam in dermis and possibly neutros in an abscess in newer lesions and has more eos than BP
IF: linear IgG and C3 on DE junction in 4/5 cases
Dermatitis herpetiformis
Super-itchy disorder c pruritic papules and vesilcles usually on the larger joints (knees, elbows, ass) caused by epidermal transglutaminase-3; thus assoc c celiac dz
- IgA deposits at the tips of the dermal papillae
Micro: Vesicles form under the epidermis
- micro-abscesses filled c neutros or fibrin deposition at the tips of the dermal papillae
*** Neutros in dermal papillae or subepidermal collection of neutros: don't get PLAID (played)*** bullous Pemphigoid
Lupus (bullous)
EBA
Linear IgA
Dermatitis herpetiformis ***
IF: IgA deposited in a granular pattern within the dermal papillae
Tx: dapsone

Dermatitis herpetiformis
Familial benign chronic pemphigus (Hailey-Hailey disease)
AD inherited dz (ATP2C1 gene [for a Ca2+ pump]) c poor cellular adhesion; a genodermatosis (??)
- "wet tissue paper" look of affected skin in neck and intertriginous areas; not as diffuse as Hailey-variant of Grover's disease
- may get infected
- Not an ab-mediated dz (negative IF)
- acantholysis should NOT involve the hair follicle (if it does, then the dx is probably pemphigus vulgaris)
Micro: "dilapidated brick wall" appearance of acantholysis
- also see acanthosis
- pinkish halo surrounds nuclei
*** I want 2C Hailey's comet 1 day ***


Hailey-Hailey disease

Darier's dz
Dare to dx Darier's dz

Keratosis follicularis (Darier's disease)
AD genetic dz (of ATP2A2, also a calcium pump), presenting c fat-like crusty lesions in places c lots of sweat glands
Micro: Acantholysis c lots of dyskeratosis, esp in lower epidermis
- more dyskeratosis, but less acantholysis than Familial b9 chronic pemphigus (Hailey-Hailey dz); and also do not have the red halo, but a blue or white halo around dyskeratotic nuclei
forms clefts and lacunae
- irregular upward proliferation of papillae lined by single layer of basal cells (villi) into the lacunae
- Grains and corps ronds (characteristic dyskeratotic cells)
Pemphigus foliaceus (PF)
Rare form of pemphigus, c more b9 course, seen in adults
- widespread patches and fragile blisters, erosions and scale crust
- blisters are induced by IgG (IgG4 subclass) autoabs against cell adhesion molecule desmoglein 1 seen in the granular layer of the epidermis
DIF: intercellular staining for IgG and C3 in affected and normal skin (net-like pattern)
Direct IF with IgG in epidermis in pt c PF


Pemphigus foliaceus (PF)
Pemphigus vulgaris
Autoimmune blistering skin disorder that is NOT pruritic
- potentially fatal, may be triggered by medications such as penicillin
IgG (IgG1 and IgG4) ab and sometimes C3 against desmosomes (anti-desmoglein, anti-epithelial cell ab, against [Desmoglein 1 and?] desmoglein 3)
- immunofluorescence shows abs around epidermal cells in a reticular pattern
Acantholysis: intraepidermal bullae involving oral mucosa
*** has a Vulgar mouth! ***
- Positive Nikolsky's sign
Histo: suprabasilar / intraepidermal blister and acantholysis
- "tombstones" - basal keratinocytes that remain attached to BM
IF: IgG and C3 deposition bwt cells in epidermis in fishnet or "chicken-wire" pattern
Tx: Prednisone, azathioprine/mycophenylate (to wean off roids)
A) Pemphigus vulgaris, B) Pemphigus follicularis with suprabasal epidermal cleavage

Paraneoplastic pemphigus
Autoimmune blistering dz in setting of internal malignancy, esp B-cell lymphoma; is heterogeneous both clinically and histologically 2/2 various combinations of epidermal adhesion or basement membrane molecules that are targeted by circulating autoantibodies
Micro: hallmark is lichenoid interface reaction / dermatitis and suprabasal acantholysis with vesiculation
Porphyria cutanea tarda (PCT)
MCC porphyria in the states; assoc c Hep C and AIDS, EtOH, iron overload and possibly inherited deficiency of uroporphyrinogen decarboxylase (in heme synth), which are found in the liver
- get blisters in sun-exposed areas (back of hands)
Subepidermal pauci-inflammatory vesiculation; thick acral skin c compact orthokeratosis;
- Caterpillar bodies - compact hyaline material
- festooning of dermal papillae (protrude into blister)
- hyalinization of blood vessels
IHC: PAS can highlight deposition of perivascular hyaline
IF: IgM and C3 in vessels (absorbed by hyaline)
Porphyria cutanea tarda c festooning of the dermal papilla (protruding into the blister)


PCT
Transient acantholytic dermatosis (Grover's disease)
Acquired dz causing crusty, pruritic papules on the trunks of old fogies
- good example of 2 patterns
1) acantholysis - keratinocytes fall apart (desmosomes lose contact with each other) and ball up
- acantholysis also seen in pemphigus vulgaris
2) dyskeratosis - cells crunched up and bright pink as they undergo cell death
- dyskeratotic cells also called grains if elongated, or corps ronds (round bodies in French) if are balled up
- often gets inflamed and can get eos beneath it (may want to do deepers to look for Grover dz)
Dyskeratosis similar to Keratosis follicularis (Darier's dz; genetic syndrome with large plaques on trunk) and acantholysis like familial b9 chronic pemphigus (Hailey-Hailey dz, usually in skin folds, and doesn't have dyskeratosis)
- may be spongiotic c rare acantholysis
- suprabasilar clefting seen
- thus can have a mix of histologic patterns of pemphigus, spongiotic, Darier's disease or Hailey-Hailey dz
Lesions are usually small and span only a few rete ridges
- the acantholysis usually spares hair follicles
Grover disease - basal layer starting to break up with acantholysis


Acantholysis in Grover disease

Acantholysis and dyskeratosis (arrow) in Grover disease
Epidermolysis Bullosa (EB)
Groups of inerited blistering dz's that lead to mechanically fragile skin
- onset at birth
- mutations in genes coding structural proteins that make up tonofilaments within keratinocytes (EB simplex), the hemidesmosome (junctional EB), or anchoring filaments (dystrophic EB)
Dermolytic or dystrophic epidermolysis is 2/2 mutations in the gene for type VII collagen (COL7A1)
- assoc c disfigruing scarring, potential limb amputation, and late SCC
Junctional (non-scarring) epidermolysis bullosa assoc c defection in the gene for Laminin 5
Keratins 5 or 10 mutations assoc c bullous ichthyosis / epidermolytic hyperkeratosis

Epidermolysis Bullosa


Bullous impetigo with subcorneal collection of neutrophils

Bullous Impetigo
2/2 gram+ cocci Staphylococcus aureus
- considered a localized form of staphylococcal scalded skin syndrome that results from the production of Staphylococcal epidermolytic toxin which targets desmoglein 1 (a protein of desmosomes found higher in the epidermis)
Micro: sub corneal collections of neuts with or without acantholytic cells
Gram stain can show gram-positive cocci in the stratum corneum
Dyshidrosis
- aka pompholyx
Type of dermatitis c itchy blisters on the palms and soles
- blisters usually form over a couple of weeks up to 2 mm, although they often recur
- usually no redness present
- name "dyshidrotic" given bc once thought that the lesion comes from problems with sweating
- about 1 in 2000 people affected in Sweden, may be related to dust mites
- blisters described as having a tapioca pudding appearance
DDx: allergy testing and culture can be done to rule out problems
- pustular psoriasis and scabies can also look similar
Tx: steroid cream
- tacrolimus and PUVA can also be tried out
Dyshidrosis


Inflammatory Dermatopathology
Acne
Hyperkeratosis, sebum overproduction, propionibacterium acnes proliferation, and inflam
Tx: vit A analog (retinoic acid), isoretinoin, spironolactone, estrogens, antibiotics, benzoyl peroxide, and can inject pimples w stroids
Allergic Contact Dermatitis (ACD)
MC in women, usually 2/2 nickel allergy, seen more in metal workers, beauticians, health care workers, cleaners, painters, and florists
- type IV (delayed) hypersensitivity rxn, usually 48-72 hours after exposure to an allergen
- can be 2/2 poison ivy
- ags initially taken up by Langerhans cells and carried to lymph nodes
- on re-exposure cytokines released, causing endothelial activation and adherence of memory T cells that release lymphokines and cause spongiotic dermatitis
- can get bacterial superinfection (impetiginization)
Micro: extensive spongiosis, initially acute spongiotic dermatitis, that evolves to subacute or chronic spongiotic dermatitis, then resolves
- can have intraepidermal vesicles, exocytosis, papillary dermal edema or perivascular lymphocytic infiltrates in upper dermis and lots of eos

ACD
Irritant Contact Dermatitis

Necrolytic Migratory Erythema
aka glucagonoma syndrome (sx include hyperglucagonemia, diabetes, glossitis, abd pain, wight loss, anemia, nausea)
Histo: Parakeratosis; holes and whiteness in middle and upper squames; dyskeratosis; necrosis and peeling of upper layers of epidermis
Spongiosis
Eczema
Psoriasiform (epidermal hyperplasia)
Psoriasis
Papules and plaques w silvery scaling, esp on knees and elbows
- inheritance is complex and polygenetic
- acanthosis w parakeratotic scaling
- inc stratum spinosum and dec stratum granulosum
- assoc w uric acid renal stones due to inc cell turnover
Auspitz sign: bleeding spots when scales scraped off
~ assoc w nail pitting and psoriatic arthritis (found in <1/3 of cases)
Acanthosis present more often in long-lastin lesions; but may not be present in pustular psoriasis or earlier lesions
Guttate ("raindrop") psoriasis is a subtype caused by triggered by Staphylococcus and can be self-limiting
Micro: Stratum corneum (which has no serum??) has collection of neutros (Munro's abscess)
- loss of granular layer; but no atypia in keratinocytes
- sandwich sign: alternating layers of neutros and parakeratosis
- windy BVs in dermal papillae
- spongiform pustules of Kogoj (???)
***Neutros in stratum corneum: Pus In Corneum, STDs (PIC STDs)***
*** Psoriasis, Impetigo, Candida, Syphilis, Tinea, Dermatitis (seborrheic) ***
Tx: Roids, UV, tar


Seborrheic dermatitis
A psoriasiform spongiotic dermatitis occurring in the seborrheic areas including the face, scalp, axilla, and groin, and is assoc c HIV and AIDS, Parkinson disease, epilepsy, neuroleptic drugs, and DM
Micro: netros crusted at edge of hair follicle, irregular epidermal hyperplasia with mild spongiosis, hyperkeratosis, follicular plugging, and mound of scale crust at the shoulder of the follicle
Seborrheic dermatitis



Seborrheic dermatitis
Interface / Lichenoid
Interface not the same as Lichenoid
Interface: vacuolization of the basal layer of epidermis, with lymphs abutting the DEJ causing death of keratinocytes (Civate bodies / colloid bodies, Satellite cell necrosis in GVHD)
Lichenoid: band of infiltrate of lymphs at DEF causing death of keratinocytes (Epidermal changes include "sawtoothing" of the rete and hyPERgranulosis)



Benign lichenoid keratosis
Benign lichen keratosis / lichen planus-like keratosis (BLK / LPLK)
Acutely developing rash (<3 mo); erythematous or pinkish papule or plaque
- dermoscopy can show remnants of pigment network, subtle blotches of brown color, clusters of grey dots and dotted, irregular linear and other shaped telangiectatic BVs
Micro: classic variant shows epidermal acanthosis c band-like lichenoid lymphocytic infiltrate
- single lymphs seen along dermoepidermal junction w/o epidermal acanthosis and adjacent lentigo
Erythema dyschromicum perstans (EDP)
- aka ashy dermatitis or dermatosis cenicienta (Cinderella in Spanish)
- b9, uncommon, presents c generalized ashy-gray colored macules on body, usually seen in Latinos and Indians
Micro: basket-weave cornified layer, slight epidermal hyperpigmentation, vacuolar alteration of basal layer, melanophages in subepidermal region, sparse superficial perivascular lymphohistiocytic infiltrate
Tx: roids, UV, pigment lasers
Erythema dyschromicum perstans

EDP

Erythema multiforme (EM)
Blistering skin disorder assoc w infx (M. pneumoniae, HSV), drugs (sulfas, B-lactams, phenytoin) cancer, autoimmune dz
- considered a Type IV rxn {2},
- MCC of EM is infectious (herpes, Mycoplasma pneumoniae) and is usually seen in kiddoes
- MCC of SJS/TEN is from MEDICATIONS (usually TMP-SMX, allopurinol, carbamazepine, lamotrigine, phenytoin, NSAIDS, cephalosporing, aminopenicillins, and quinolones)
- has IgM deposits
- as a rule, involvement of the lips and oral mucosa is present
EM Minor: usually 2/2 infx (a hypersensitivity rxn), #1 is HSV
- Mucous membrane involvement is mild
EM Major: usually secondary to drugs (sulfonamides, NSAIDs), one or more mucous membranes typically affected, most often oral mucosa
Presents w MULTIple types of lesions: macules, papules, vesicles, and target lesions (pathomneumonic central core of blister or necrosis surrounded by erythema)
- keratinocyte injury mediated by CD8 T-cells homing in on the skin, concentrated in the central portion, with CD4 T-cells in the peripheral macular erythematous area
- likes to form in palms and soles, where antigen processing is high; mucous deposits may be assoc c CTD {2}
- basal vasculopathic (basovacuolar degeneration) are small holes obscuring the dermal-epidermal junction
If assoc c fever and very extensive with NECROSIS, think SJS, esp if in a kiddo
- very dangerous; involves sensitive areas (mucosa and genitals)
- TEN an even worse variant on this spectrum, with diffuse necrosis and skin sloughing (> 30%, vs SJS <30%)
-- TEN may be treated with IVIG, which binds circulating FAS responsible for its pathogenesis
CD8 lymphs damage keratinocytes in the skin with IgM deposits due to infx (Mycoplasma pneumoniae, EBV, HSV, histo), drugs (sulfas, penicillins, phenytoin, barbs, ASA), ca, autoimmune
- see variety of lesions (hence MULTI-FORME): target lesions (pale center with red periphery), macules, papules
More severe (life-threatening) form is Stevens-Johnson Syndrome (SJS), which is aka erythema multiforme major, which involves mucosal surfaces in addition to skin
- involves <30% of skin surface; if >30% --> Toxic Epidermal Necrolysis (TEN)
-- Both of these have high mortality rates
- if 10-30%, known as SJS/TEN overlap
Histology: Interface dermatidities - superficial lymphocytic infiltrates around vessels which migrate up to DEJ causing edema and eventually invade upper dermis levels
- vacuolar interface change, scattered necrotic keratinocytes, interface lymphocytes
Normal corneum (basket-weave orthokeratosis) with crazy necrosis underneath corneum which is out of proportion to the amount of inflam (primarily lymphs in early phases) and basal layer vacuolization
- MCC is HSV orolabial infx
- interface dermatitis classified by type of infiltrate or by degree of inflam (if lots of lymphs, coined lichenoid interface dermatitis)
-- more likely to see eos if caused by drugs {2}
The basement membrane may be at the top of the blister (if separation occurs subepidermally) or underneath the blister if occurs at DEJ
DDx: SSSS (has more superficial level of blistering)
- generalized fixed drug eruption (rare subset of fixed drug eruption that presents with more widespread annular vio;aceous lesions and can become bullous; can be difficult to differentiate, although with fixed drug eruptions usually have superficial and deep perivascular mixed inflammatory infiltrates, often with eos)
- Acute graft versus host disease (rarely has mucosal involvement)
- morbiliform drug eruptions (never has mucosal involvement, and do not progress to widespread skin sloughing)
Tx: normally resolves in 7-10 days
- for SJS and TEN, the first step in tx is the immediate identification and withdrawl of the causative drug (Abate Derm Urgencies and Emergencies, Archives of Pathology 2019)
Px: mortality as high as 30%, depends on the amount of body surface area involved, age of pt, heart rate, presence/absence of underlying malignancy, and lab values (BUN, glucose, bicarb)
- the prognostic factors taken into a score called SCORTEN
- can have long-term sequelae such as scarring, esophageal stricture, genital adhesions, chronic bronchitis
- pts usually transferred to burn units

Erythema multiforme

Stevens-Johnson syndrome


EM
Erythema-Multiform-like TEN

Lichen nitidus
Crusty, hemorrhagic, pin-sized papules, which can be on the buttox of youngins
- shows "ball in claw" pattern of inflam where lymphohistiocytic infiltrate localized to one to a few dermal papillae surrounded by elongated retes (usually not seen on bx)

Lichen nitidus

Lichen nitidus

Lichen planus

Lichen planus
Middle aged pt c lesions on flexor surfaces and in oral mucosal surfaces (in 3 of 4 pts)
- may be assoc c Hep C, but etiology is unknown
- Wickham striae: white lines on surface
- Koebner's phenomenon - scratching spreads the lesion
*** Pruritic Purple Polygonal Papules Planar***
Histo: Epidermal hyperplasia c prominent granular layer (wedge-shaped hypergranulosis) and lichenoid infiltration pattern with irregular epidermal acanthosis causing a sawtooth rete ridges appearance w/o parakeratosis or eos
- Civatte bodies (in epidermis), cytoid bodies, and coloid bodies (Melanoderma???, in papillary dermis) which are apoptotic squames and stain c PAS and Collagen IV
- not likely if parakeratosis is present
- Max- Joseph spaces: subepidermal clefts
If lichenoid and psoriaform --> do IHC for Treponema!! (Warthin starry is "Worthless" starry usually)
If looks like LP and has eos --> consider lichenoid drug eruption
IF: IgM deposits in colloid bodies at dermal junction, linear and shaggy deposition of fibrinogen at DE junction
Lichen planopilaris
Inflammatory scarring alopecia that usually involves the frontal scalp and can present c lichenoid papules on other parts of the body
- Scarring of the follicles
Micro: lymphocytic (lichenoid) infiltrate of the upper third of the follicle
- decreased inflam c inc dermal depth
- colloid bodies may be seen in superficial dermis around follicular epithelium
- may have interfollicular involvement (usually doesn't)
Ddx: Discoid Lupus - has superficial and deep inflammation; does give interface changes in interfollicular epithelium; is another part of the dx in of scarring alopecia



Lichen planopilaris
Frontal Fibrosing Alopecia
Named 2/2 clinical distribution
Micro: similar (identical?) to lichen planopilaris, with lichenoid inflammation and subsequent follicular epithelial damage and scarring in the vicinity of follicular infundibula
Androgenetic alopecia
- aka male pattern baldness
Mediated through DHT on outer root sheath and follicular papillae in characteristic clinical distribution or pattern
Micro: increased numbers of smaller indeterminate and vellus-sized hairs that are progressvely lost over time
- may occus with chronic telogen effluvium, such that a low grade increase in catagen/telogen follicles may be notes
Lichen sclerosus
aka Lichen sclerosus et atrophicus (LSA)
Atrophic hypopigmented patches / plaques on anogenital region / upper trunk / neck usually in perimenopausal women; may co-exist c lichen planus and morphea
- assoc c HLA DQ7
- same thing as balanitis xerotica obliterans on glans penis
***Red White and Blue!!!*** Red = compact stratum corneum, White = papillary dermal pallor, Blue = band of lymph infiltrate ***
Micro: orthokeratotic hyperkeratosis c epidermal artophy, hydropic degen of basal layer, vacuolar interface dermatitis and follicular plugging
- papilalry dermis replaced by edematous hypocellular staining band c chronic inflam (papillary dermal pallor c underlying lymph band)
- there is hyalinized, glassy collagen in the upper epidermis (which has probably undergone some inflam process, collagen bundles packed really close together) with a band of lymphocytic and histiocytic inflam underneath and a normal collagen underneath the inflam
- will still see vacuoles at the base of the epidermis where the lichenoid reaction used to be (starts as lichenoid process at skin surface and then moves away from epidermis and moves deeper into dermis)

Lichen sclerosus et atrophicus
Lichen sclerosus et atrophicus - hyalinized collagen in upper epidermis serparated by band of inflam from normal collagen in lower epidermis

Lichen simplex chronicus
Thickened lichenified plaques from long-standing rubbing or scratching
- usually seen in pts c atopic dermatitis or chronic contact dermatitis
- prurigo nodularis (Picker nodule) is the same basic process but presents as a circumscribed hyperkeratotic papules or nodules, usually on the extremities
Micro: marked irregular hyperplasia of the epidermis c hypergranulosis, orthohyperkeratosis and streaking fibrosis of the dermis
Lichen simplex chronicus

Lichen striatus
- Blaschko linear acquired inflammatory skin eruption (BLAISE)
Asymptommatic dermatosis of unknown etiology, F>M, 5-15 yo
- rash in linear distribution following Blaschko lines, which are erythematous or flesh-colored scaly papules
- nail changes usually seen including onycholysis, splitting and nail loss; atopy in 6/10 pts
Tyndall effect - light refracting out at different wavelength
Spongiotic dermatitis + lichenoid / interface
- basal layer liquefaction
- lichenoid lymphocytic infiltrate
- superficial extending deep
- syringocentricity
- mild to psoriaform acanthosis
Lymphs around eccrine glands?
- think lupus, lymphoma, and rarely tinea
Lichenoid drug eruption
Has similar features to other lichen rxns, except usually has more eos
Lichen striatus. A, Erythematous, scaly, papular eruption following the lines of Blaschko on the right leg. B, Detail of lichenoid lymphocytic interface dermatitis. C, Lymphocytic infiltrate involving eccrine gland coils (B and C, H&E; ×100).

Morphea / scleroderma
Morphea (aka localized scleroderma( is the MC of the sclerosing disorders
- can have variable presentation
Group of dz's, with deep dermal sclerosis always there, and can go all the way down to the bone
- some see lichen sclerosus as a superficial form of morphea
Rectangular punch bx c trapped eccrine glands 2/2 loss of adventitial fat, thick closely packed red ollagen bundles in lower dermis
- no interface dermatitis, but can see some inflam at lower dermal levels
- usually early signs are a superficial and deep perivascular lymphoplasmacytic infiltrate c varying amts of perieccrine inflam
- later can see collagen fibers thicken and become hyalinized and eosinophilic
- eccrine glands lose their surrounding fat and can disappear completely
Scleroderma usually has inc deep dermal mucin, and is usually on the upper back
Morphea


Morphea (localized scleroderma)

Lupus erythematosus
Vacuolar or lichenoid inflam changes c lymphs in almost every hole, RBC extravasation into epidermis
- mucin bwt collagen bundles in dermis (stains c PAS-AB)
- compact and follicular hyperkeratosis
- BM thickening
- vertical columns of lymphs and periadnexal lymphs
- follicular plugging
- melanoderma (melanocyte incontinence)
- may see inflam of fat (panniculitis) and adnexa
-- nodular lymphoid aggregates fairly specific for lupus (may be called lupus profundus (aka lupus panniculitis)); usually seen on extremities, and also has prominent plasma cells and hyaline necrosis (eosinophilic deposition between adipocytes) with hyalizing fat necrosis
- no significant spongiosis, though can see hydropic alteration of basal layer (???)
IF: full house (continuous granular band of IgG/A/M and C3) at BM
Interface dermatitis – Lupus Erythematosus
• Lymphocytes abutting the DEJ
• Squamatization of the basal keratinocytes
• Compact orthokeratosis/hyperkeratosis, often with follicular plugging (discoid variant)
• Superficial and deep perivascular and periadnexal predominately lymphocytic inflammatory infiltrate (eosinophils are NOT a feature)
-- Dermatomyositis (DM) has essentially the same histology
• Increased dermal mucin
• Thickened basement membrane (seen on PAS)
• Granular pattern of IgG, IgA, IgM and C3 along
basement membrane seen on DIF (“lupus band test”)
Neonatal Lupus
- self-limiting disorder 2/2 maternal autoantibodies crossing placenta, can lead to neonatal heart block and arrhythmia
- micro: ratty basal layer with vacuolar interface changes and necrotic keratinocytes that extend into adnexal epithelium
- dermis with prominent mucin
Lupus erythematosus`

Discoid lupus - Vacuolation of basal epidermis (red), follicular plugging (blue), hyperkeratosis (green), inflam around superficial and deep vessels around hair follicle (yellow)



Pityriasis lichenoides
Rare cutaneous dz of unknown etiology
- encompasses spectrum of clinical presentations ranging from acute papular lesions that rapidly evolve into pseudovesicles and central necrosis (PLEVA) to small scaly papules (Pityriasis Lichenoides Chronic [PLC])
- lesions can self-involute and resolve over weeks and/or new lesions occasionally can appear in crops, waxing and waning spontaneously for months to years
Micro: parakeratosis, spongiosis, mild epidermal acanthosis
- basal keratocytic vacuolar change
- epidermal exocytosis of lymphs and erythrocytes
- moderately dense, wedge-shaped lymphohistiocytic infiltrate extending to the reticular dermis
Pityriasis lichenoides et varioliformis acuta (PLEVA)
Vacuolar interface dermatitis c a lymph in every vacuole and transepidermal elimination of RBCs
- no papillary dermal fibrosis
- neutros marginate in the deraml BVs
- compact hyperkeratosis and focal parakeratosis often with neutrophilic scale crust
- dyskeratotic cells in epidermis
- neutrophils in dermal vessels
***
Parakeratosis
Lichenoid infiltrate
Extravasated RBCs
V-shaped infiltrate
Apoptotic keratinocytes
***
Spongiosis c intraepidermal vesicles
- no vasculitis unless ulceronecrotic variant
Mucha-Habermann disease
PLC - much like PLEVA but milder
Pityriasis lichenoides
Pityriasis chronica et acuta


PLEVA


PLC
Pityriasis Rosea (PR)
- Acute, self-limited dermatosis
- Presents as oval, salmon-pink papulosquamous lesions on trunk and prox extremities which are usually preceded by a "herald patch"
- lesions can form a "christmas tree" distribution on the trunk
Micro: Mild epidermal spongiosis c mounded parakeratosis and extravasation of erythrocytes into papillary dermis
- sometimes admixed eos
PR - Herald patch


PR
Parakeratosis

PR

Mounded parakeratosis in Pityriasis Rosea
Porokeratosis
Column of pink parakeratosis shooting out of skin at 45 degree angle (the cornoid lamella) -- what happens between the cornoid lamella stays between the cornoid lamella (all the atypia is between the cornoid lamella) -- kinda looks like a train billowing smoke
- can have some lichenoid inflam (??)

Porokeratosis`

Porokeratosis
Syphilis
Slender acanthosis with basal-layer vacuolar interface inflam
- vessels seem to not have a lumen 2/2 swelling of vascular endothelium
- pink cytoplasmic background in inflam
- can see lots of plasma cells
DDx: lupus (if lichenoid and psoriaform do IHC for treponema!!)
Syphilis

Tuberous xanthoma
Yellow nodules MC on elbows, knees and butt and assoc c problems c lipid metabolism
Fibrotic nodule c occasional foam cells throughout dermis and possibly cholesterol lefts
- fibroblasts found in older lesions
Eruptive xanthoma
Yellow papules c red halo, assoc c inc chylomicrons in blood and deficiencies in LPL; MC on butt or thigh
- Dermal lipid deposition in early lesion is so strong that histiocytes are unable to eat it all, so it gets deposited as extracellular lipid
Micro: foam cells and extracellular lipid with scattered lymphs and neutros in early lesions
Xanthelasma
Sharply demarcated yellowish deposit of cholesterol under the skin, usually on or around the eyelids
- there is no high-quality evidence that these xanthelasma deposits are related to blood LDL levels or inc risk of atherosclerosis
Tx: trichloroacetic acid peel, surgery, lasers, or cryotherapy


Xanthelasma
Perivascular
Superficial and Deep Perivascular Inflammation
*** 8 L's ***
Light reactions, Lupus, Lues (syphilis), Leprosy, Lichen striatus, Lymphoid proliferations (lymphoma, reactive lymphoid hyperplasia), Lipoidica, Lepidoptera (parasites and arthropods)
Drugs
Dermatophyte infection, Reticular erythematosus mucinosis, Urticaria, Gyrate erythemas, Scleroderma
Mixed infiltrate c Eos?
If deep (eccrine glands/ follicular structures) --> arthropod, fungal, scabies or parasite
- if angiocentric --> drug
If paucicelular and interstitial --> urticaria
If edema/blister/festooning --> BP
If spongiosis --> contact, erythema toxicum neonatorum (ETN)
If vesicular --> incontinentia pigmentii (IP)
If vascular --> angiolymphoid hyperplasia ...?
Minimal change ddx
*** I VACUUM DOG PUS ***
Ichythyosis
Vitiligo
Argyria
Candida
Urticaria
Urticaria pigmentosa
Macular amyloid
Dermatophyte
Onchocerciasis
Gold
Psoriasis-Guttate
Ulerythema Ophyrogenes
Seb Derm/Scleroderma
Drug reactions
- good luck dx'ing on a bx; mostly just done to prove that it is not something else
Dermal Edema DDx ???
Sweets - sea of neuts
Orf - Ulcer, net like degeneration
DH dermatitis herpetiformis
ACD
PMLE - Polymorphous Light Eruption
Anthrax
Pernio
Pernio
looks a lot like PMLE, except is on acral skin; aka chilblains, idiopathis vs lupus chilblains, best distinguished on serology and presence of other SLE stigmata; lupus chilblains almost exclusively in women during winter, idiopathic pernio morelikely in males given inc prevalence of outdoor activities
Eosinophilic cellulitis
aka wells syndrome
Recurrent non-infections bilateral cellulitis
may get a greenish hue
Inc IL-5
Responds to steroids
Micro: tons of eos superficial and deep
Flame figures - collagen coated in eosinophilic granule major basic protein
Eosinophilic cellulitis - Wells


Flame figure, Wells
Eosinophilic Fasciitis
Hyalinized thick fascia, variable infiltrate of lymphs plasma cells,
- aka Schulman's syndrome
Arthropod bite
Red pruritic papules, can be ulcerative
Micro: Superficial and deep perivascular and interstitial inflam made of lymphs and eos c overlying spongiosis of epidermis
Eos underneath ulcerated skin in an arthropod bite

Kyrlie's disease
Epidermal hyperplasia c hyperkeratotic plug, FB giant cells sometimes
Granulomatous Dermatitis
Five patterns:
1) Sarcoidal - Prototype is sarcoidosis
– Epithelioid cells and giant cells with asteroid bodies
– Naked granulomas (little or no peripheral lymphocytes/plasma cells)
2) Tuberculoid - Prototype is tuberculosis; +/- caseation necrosis
– Langhans type giant cells (horseshoe shape)
3) Necrobiotic/Palasaded - Prototype is Granuloma Annulare
– Epithelioid histiocytes, lymphocytes and occasional giant cells with areas of “necrobiosis” (altered collagen)
4) Supprative - Has associated neutrophils
– Infectious cause likely, also could include pyoderma gangrenosum and ruptured cysts/folliciles in this category
5) Foreign Body (exogenous or endogenous) – Be sure to polarize
6) Xanthogranulomas
7) Miscellaneous – ie. Interstitial granulomatous dermatitis, Interstitial granulomatous drug reaction, Actinic granuloma (of O’Brien)
Pyoderma gangrenomum


Pyoderma Gangrenosum
Associated with Ulcerative Colitis
Treatment:
No NOT surgically debride the lesion, will spread even more!!! (Koebner phenomenon)





pyoderma gangrenosum
pyoderma gangrenosum
pyoderma gangrenosum
pyoderma gangrenosum
1 - 4
<
>
Ecthyma gangrenosum
Seen in immunocompromised patients , where bacteria invade and infiltrate vessel walls and perivascular spaces causing vascular necrosis and ulceration of overlying epidermis
- usually has minimal inflammation
Medical emergency - need to alert clinicians!!
Ecthyma gangrenosum - necrotizing vessel with thrombus surrounded by bluish bacteria


Graft Versus Host Disease (GVHD)
Nonspecific morbilliform eruption in HSCT patients
- vacuolar interface dermatitis, should have clinical hx compatible c GVHD (chemotx)
- in early stages, can be histologically indistinguishable from other common rashes, like biral exanthems or drug eruption in the post-transplant period
Grade 0 - Normal skin
Grade 1 - Subtle vacuolar alteration of the DEJ
Grade 2 - Dyskeratotic cells in epidermis and/or follicle, dermal lymph infiltrate
Grade 3 - Fusion of basal vacuoles to form clefts/subepidermal vesicle formation
Grade 4: Separation of epidermis from dermis, with full thickness epidermal necrosis
Tx: systemic steroids
Chronic GVHD can mimic a lot of skin dzs, usually scleroderma or lichenoid



2 - 2
<
>


Acute graft-versus-host disease (aGVHD). A, Characteristic morbilliform eruption of the trunk in a patient with aGVHD. B, Erythema, bullae, and epidermal detachment is a relatively rare and severe manifestation of aGVHD and would have high-grade histologic features. (Photos A and B are courtesy of Andrew Johnson, MD, Summit Dermatology, Colorado Springs, Colorado.) C, Early aGVHD with a pauci-inflammatory dermis, basal vacuolization, and few necrotic keratinocytes. D, Acute graft-versus-host disease with basal vacuolization, necrotic keratinocytes, and lymphocytes with prominent exocytosis into the epidermis. E, Higher-power image demonstrating prominent basal vacuolization. Note the interface lymphocytes at the dermal-epidermal junction and resultant hydropic degeneration of the basal keratinocytes, which are becoming vacuolated and disorganized.
F, More advanced aGVHD with additional feature of subepidermal clefting. G, Severe aGVHD with diffuse subepidermal clefting leading to dermoepidermal separation and blister formation. H, High-power image demonstrating prominent satellite cell necrosis (epidermal lymphocytes adjacent to necrotic keratinocyte), a classic feature of aGVHD. Note the randomly enlarged atypical keratinocytes; this is epidermal dysmaturation due to chemotherapy effect. I, Prominent lymphocyte exocytosis seen in a case of aGVHD with hair follicle involvement (hematoxylineosin, original magnifications3200 [C, G, and I],3400 [D, E, and F], and3600 [H]). (Dermatologic Urgencies and Emergencies—Abate et al; Arch Pathol Lab Med—Vol 143, August 2019)
1 - 2
<
>
Annular Elastolytic Granuloma
Uncertain etiology
- presents c annular erythematous plaques usually on sun-exposed areas, usually sudden onset
Micro: elastin degeneration, MNGCs, elastophagocytosis
Tx: hydroxychloroquine


Annular Elastolytic Granuloma
Lymphomatoid Granulomatosis (LYG)
Pts present c multiple plaques, papulles, nodules, constitutional sx, and pulmonary sx, usually pts 30-50 yo, 2M>1F, immunodeficient pts
- multisystem lymphoproliferative dz 2/2 B-lymphs latently infected c EBV
- cutaneous lesions seen in 1/3 of pts which can be ulcerated, usually seen more on the extremities, but can have some lesions on the trunk
Micro: lymphocytic or lymphohistiocytic infiltrate c periadnexal or perivascular distribution in the dermis or underlying fat
- MNGCs may or may not be seen
- poorly formed granulomas can be seen in the subcutaneous tissue, well-formed granulomas are rare
- angioinvasion and angiodestruction are seen in the majority of cases, but is not needed to make the dx
IHC/ISH: EBV + B-cells can be seen in skin bx, but are usually more sparse than that seen in pulmonary bx using EBER-1 or EBER-2 (Epstein Barr virus encoded RNA)
- can be graded based on the amount of EBV-positive B cells, with grade 1 having <5 per HPF, grade 2 having 5-20 /HPF, and grade 3 with >20 /HPF
DDx: if sheets of atypical B cells are seen, the dx of DLBCL should be considered rather than LYG
- Wegener granulomatosis, extranodal NK/T cell lymphoma, nasal type lymphoma, PTLD, other lymphomas
LYG


Rhythmic Paradoxical Eruption (Macaulay)
Group of recurrent skin eruptions with self-healing b9 clinical course, but showing a malignant lymphoreticular process
- lesions begin as skin-colored non-painful papules and nodules that transform to ulcerated purplish tumors up to 2-3 cm
Micro: scale-crust and ulceration of surface
- epidermal hyperplasia c edema of papillary dermis c lots of erythrocytes
- lots of neuts in epidermis
- dense diffuse or nodular infiltrate in dermis with lots of atypical mononuclear cells and some multinucleated cells in a mix of small lymphs, histiocytes, eos and varying amts of neuts and plasma cells
- occasional Reed-Sternberg-like cells
- neuts present in vessel lumina
- scattered nuclear dust in dermis
- infiltrates can extend to subcutis
DDx: Hodgkin lymphoma (has clear Reed-Sternberg cells and lots of eos), tumoral mycosis fungoides (lots of plasma cells in infiltrate and tendency to involve epidermis c atypical convoluted lymphs
Px: even w/o tx, most lesions heal in months c a scar
- about 10-20% of cases evolve to malignant lymphoma or Hodgkin dz
Rhythmic Paradoxical Eruption (Macaulay)
Papular Acrodermatitis of Childhood
- aka Gianotti-Crosti disease
Cutaneous rxn possible 2/2 HBV or EBV antigenemia, clinically c abrupt onset of discrete, flat-topped erythematous papules in groups localized symmetrically to cheeks, buttocks and etremities of kiddos 1-6 yo assoc c fever and lymphadenopathy
Micro: focal parakeratosis overlying small wedge-shaped lesion
- focal spongiosis in upper epidermis c atypical lymphs
- slight psoriasiform hyperplasia
- marked edema of papllary dermis and extravasation of RBCs
- moderately dense superficial and deep perivascular infiltrate made of lymphs and histiocytes
DDx: Papular eczematous dermatiitis (differentiated by involvement of superficial vessels alone and absence of atypical lymphs in spongiotic foci)


Gianotti-Crosti dz
Granulomatosis
Juvenile xanthogranuloma
Isolated yellow papule in kids or adults, on upper body or in eye - thus can be assoc c glaucoma and amblyopia
- assoc c NF1, juvenile CML, Niemann-Pick
Histo: dense mononuclear infiltrate c foamy histiocytes and formation of Touton GCs
- overlying dermis looks flattened; inc eos common
IHC: (+) CD56 / HAM65, S100


JXG
Granuloma annulare
B9, self-limited dermatosis c raised annular lesions on dorsum of hands/legs (sun exposed areas) that can be generalized
- assoc c morphea, chronic hep C, autoimmune thyroiditis, secondary hyperparathyroidism, Plummer's dz, MDS, DM
- resolved in <2 yrs but amy persist and can spontaneously regress after bx
Can have interstitial pattern c busy dermis at low power or palisading pattern c histiocytes surrounding altered dermal collagen and mucin
Micro: mid dermal necrobiotic collagen with mucin surrounded by palisading histiocytes, fibroblasts and lymphs
- focal and patchy with rare plasma cells and no cholesterol clefts
- sometimes foreign body GCs, vasculitis and mucin
- may need multiple sections to see necrobiotic collagen
IHC: (+) vimentin, lysozyme and CD68 in histiocytes, PAS-AB in interstitial mucin
- negative HAM56 in histiocytes

Granuloma annulare




Langerhans cell histiocytosis
- aka histiocytosis X
- see also: Bone Pathology
Gross: pink plaques that can look like amelanotic melanomas
- pagetoid spread possibly
Micro: affects DE junction and corium
- nuclei look like kidney beans
- acutely, inflam goes after follicles
IHC: (+) S100, CD1a, langerin, peanut agglutinin
EM: Birbeck granules

Langerhans cell histiocytosis
Necrobiosis lipoidica (NL)
MC in pts c DM, thus the original name diabeticorum (though affects <1% of pts c DM) usually atrophic yellow depressed plaques in pretibial area
Micro: rectangular punch bx 2/2 sclerosis c horizontal acellular pale degenerated collagen, top to bottom and side to side involvement with plasma cells in deep dermis
- large area of necrobiosis in dermis and subQ fat; usually c epithelioid histiocytes, giant cells and a well-formed granuloma
- no mucin !!!
- early lesions can look like interstitial granuloma annulare
- has degenerated collagen in the center of the pallisade (mucin in granuloma annulae and fibrin in a rheumatoid nodule)
DDx: mucin in granuloma annulae and fibrin in a rheumatoid nodule
Necrobiosis lipoidica diabeticorum


Necrobiosis lipoidica


NL- Tiers of necrobiotic collagen alternating with fibrosis
Necrobiotic xanthogranuloma (NXG)
Rare dz of unknown etiology c presence of papules and nodules c predilection for periorbital area, though can also been in extremities or trunk
- most pts c NXG have assoc monoclonal paraproteinemia (usually IgG kappa)
Micro: xanthogranulomatous infiltration in mid dermis extending to subcutaneous tissue c extensive areas of necrobiosis
- granulomatous infiltrate show epithelioid and foamy histiocytes c lots of Touton GCs admixed c chronic inflam response
- cholesterol clefts often seen in foci of necrobiosis
Necrobiotic xanthogranuloma NXG

Reticulohistiocytoma

Reticulohistiocytosis
LCH at or near birth that spontaneously resolves and has cutaneous nodules
- usually on the back of the hands (??)
- solitary reticulohistiocytoma is asymptomatic, though multicentric reticulohistiocytosis assoc c severe destructive arthritis, usually of the interphalangeal joints of the hands
- 15% have assoc autoimmune dz, 1/4 assoc c internal malignancy
Micro: diffuse infiltrate of large histiocytes c ground glass cytoplasm, like ground glass
IHC: (+) CD45, CD68, CD11b, HAM56
- neg: S100, CD1a
DDx: JXG
Rheumatoid nodules
Assoc c adult and juvenile RA and rheumatic fever, found on extensor of elbow and other joints and can occur in abdominal wall and heart; usually in subQ at sites of trauma or pressure points
Micro: in subQ fat / ST and can go to deep reticular dermis c fibrin deposits and necrobiosis in center on nodule surrounded by well developed palisading histiocytes, vascular granulation, lymphs, plasma cells and occasional leukocytoclastic vasculitis
- Has Fibrin in the granuloma
- granuloma annulare and necrobiosis lipoidica are more superficial
-- mucin in granuloma annulae and degenerated collagen in necrobiosis lipoidica
Rheumatoid nodule with fibrin granuloma


Sarcoidosis
Dx of exclusion; "Naked" granulomas formed by epithelioid histiocytes and MNGCs in a nodular pattern c little lymph inflam and no necrosis
- can see Asteroid bodies and Schaumann bodies, but not specific
Should diagnose sarcoidal granuloma after ruling out other infectious etiologies
Sarcoidosis

Panniculidities
Alpha-1 antitrypsin deficiency panniculitis
Lobular or mixed pattern
- neuts >> lymphs
- fat necrosis c foamy macrophages
- cystic changes in fat lobule
- ulcertion
- inflam in dermis
- fibrosis later
- can look similar to Weber-Christian dz on path
Cytophagic Histiocytic Paniculitis
Bean bag cells
Erythema infectiosum
- aka Fifth disease
One of the several possible manifestations of parvovirus B19
- is also called slapped cheek syndrome
- is part of the list of rash-causing childhood diseases, including measels (1st), scarlet fever (2nd), rubella (3rd), Dukes' dz (4th, however is no longer widely accepted as distinct) and roseola (6th)
Erythema infectiosum

Erythema Nodosum
An acute, nodular erythematous eruption limited to extensor aspects of lower legs, likely a hypersensitivity rxn, MCC is Streptococcal infx
Micro: Almost exclusively septal panniculitis that can be seen c granulomatous inflam (lymphocytic c giant cells), edema and fibrosis in the septum without causing necrosis in the fat lobule (AAT-1 deficiency can cause a similar picture of necrosis)
- neutros can be found in septum in acute phase
- may be assoc c coccidiomycosis, histoplasmosis, TB, leprosy, streptococcal infx (acute pharyngitis), or sarcoidosis
- Meischer's granuloma - cleft in the central portion of a granuloma (MC in chronic lesions)

Erythema nodosum
Erythema nodosum

Lipodermatosclerosis
Clinically looks like tapering of the legs above the ankles, resembling an upside down Champagne bottle, with brownish-red pigment and induration
- assoc c venous stasis / insufficiency
- lipomembranous fat necrosis (fat microcysts lined by eosinophilic material with crenelated appearance) and septal fibrosis characteristic
Sometimes overlying stasis dermatitis changes
- lobular or mixed pattern
- fat necrosis or sclerosis
- foamy macrophages
- lymphocytes
-lipomembranous changes
- arabesque bodies ("frost on a window")
- cystification
Lipodermatosclerosis


Lipodermatosclerosis
Nodular vasculitis / Erythema Induratum (EI) of Bazin
Usually in calves that can have drainage of liquefied fat, now is very rare; historically was assoc c cutaneous TB
- predisposing factors include abnormal amt of subQ fat, thick ankles, and abnormally poor arterial supply (which causes low-grade ischemia of the ankle region)
- the ankles become insensitive to temperature changes, and can turn blue when exposed to cold
- chilblains can be present
- called nodular vasculitis if PPD negative; EI if PPD positive
Lobular panniculitis with vasculitis
- caseating necrosis or fibrosis possible
"Chicken soup" necrosis (often caseating) of fat lobule c MNGCs
- in septum may see nodular neutrophilic vasculitis

Erythema induratum
Erythema infectiosum (fifth disease)

Pancreatic panniculitis
Predominantly lobular pattern
- mixed infiltrate
- fat necrosis c "ghost cells"
- saponification = basophilic deposits of fatty acids and calcium deposits
Pancreatic panniculitis

Sclerema neonatorum
Very bad, kids die young, crystaloid panniculitis, no immune response
Subcutaneous fat necrosis of the newborn
Kiddos survive, has more inflammation than sclerema neonatorum
- also has needle shaped clefts
-- needle-shaped clefts can also be seen in steroid-assoc fat necrosis
- assoc c hypercalcemia
Needle-shaped clefts of Subcutaneous fat necrosis of the newborn

Superficial thrombophlebitis ...
Subcutaneous panniculitis-like T-cell lymphoma
ab
- younger, self healing w/o ulceration
- 82% 5-yr survival
gd (HPS, massive necrosis/apoptosis)
- 11% 5 year survival
*** want your kids to get A's and B's, not D's ...***
- px of AB is much better
Vasculitic
Acute febrile neutrophilic dermatosis (Sweet's syndrome)
Assoc c myeloprolif dz, pts get red hot lesions after a URTI
- clinically presents as painful, dark red crusted plaques / nodules and assoc fevers
Micro: Marked edema of the papillary dermis (like a pink band under the epidermis) and neutrophilic dermal infiltrate
- Focal LCV (similar to below, but not necessarily effecting vessels) c space-dust neutrophils often seen
DDx: infx (should r/o c stains or culture)
Sweet's syndrome

Leukocytoclastic vasculitis (LCV)
Pruritic and palpable, sometimes c livedo reticularis or stellate infarcts
- MCC are Strep and meds
- is a vasculitis of the post-capillary venules
- usually idiopathic, but sometimes can be caused by drugs, infx, chemicals, cancer or systemic dz
- on req, may hint at this dz c "palpable purpura", most diagnostic biopsy from fresh lesion (from 18-24 hrs old)
- if not in the skin, usually involves joints, GI and kidneys
Micro: neutros invade the perivascular region; vessel wall may be expanded, due to deposition of fibrin in fibrinoid vascular necrosis
- RBC extravasation
- karyorrhexis around vascular space looks like space dust; or dismembered ants and scattered ant heads (leukocytoclasis)
- eosinophils and sometimes fibrin thrombi can be seen
PAS+, diastase resistant
DIF: IgG, M or complement in granular pattern
Px: good if not systemic
Leukocytoclastic vasculitis

Perniosis / pernio / chilblains
Localized inflammatory skin lesion on acral skin, esp fingers and toes, usually after cold exposure
Histo: Classically superfiical and deep inflammation, with variable vessels wall alterations usually features of vasculitis and characteristically perieccrine accentuation of inflammation
- usually also papillary dermal edema with or without vascuolar interface alterations
- Fluffy edema and expansion of BV walls w/o fibrin deposition and superficial and deep perivascular lymph inflam seen on acral skin


Perniosis
Tumid Lupus Erythematosus
Micro: Patchy perivascular lymphocytic inflam
- mucin in dermis and lymphocytes found in eccrine coil
Urticarial vasculitis
Characterized by urticarial wheals that typically last >24 hours and resolve with bruising
Histo-continuum bwt chronic urticaria and conventional LCV
- clinical variant of LCV
- sparser than LCV
- more neuts
Granuloma faciale (GF)
GF is actually a misnomer, bc there are no granulomas
Grenz zone (so does lymphoma and leprosy)
- diffuse infiltrate (eos numerous), PMNs, lymphohistiocytc
- LCV
- hemosiderin
- hemosiderin
DIF: IgG complement on BMZ+ around vessels
EED: neuts>eos, NO grenz
Granuloma faciale





EED

Erythema Elevatum Diutinum (EED)
Small vessel vasculitis, usually symmetric on extensor surfaces over joints, with fibrinoid changes in dermal BVs c PMN infiltration
- like LCV but c prominent interstitial neuts
- also eos, histios, lymph and plasma cells
- Onion-skin like perivascular fibrosis also seen in granuloma faciale
- older skins can have extracellular cholesterol clefts, and usually become fibrotic with a laminated appearance
- has acute histologic features despite chronic course
- dense neut infiltrate (can look like Sweet's)
- fibrosing LCV
- very hard to distinguish from granuloma faciale except for location
Atrophie blanche
epi atrophic +/- spongiosis
- "crayon-red" vessel plugs
Septic vasculitis
Direct toxin/immune vessel damage
- often 2/2 septic SBE, Neisseria, Pseudomonas
Micro: sub/intraepidermal pustules and necrosis
- Platelet-fibrin thrombi c PMNs +/- neutrophilic LCV
Hydrophilic polymer vasculopathy
May show PXE-like changes of the fat(?) can be seen in longstanding iflammatory dermatoses (?) such as lipodermatosclerosis, lichen sclerosus, morphea profunda, erythema nodosum
Hydrophilic polymer vasculopathy


Infiltrates
Pigmented Pruritic Eruption
Lichenoid infiltrate, extravasated RBCs
- neutrophils give you fibrin, which you do not see here, bu you do see in LCV
- has normal epidermis, some spongiosis or focal keratosis
- endothelial swelling and perivascular lymphs (lymphocytic vasculitis)
- hemosiderin
Pigmented Purpuric Dermatosis
- aka capillaritis
- is not a true vasculitis
- has multiple variants (Schamberg's has progressive pigmented purpura, asymptomatic cayenne pepper red-brown telangiectc patches; also Lichen aureus, Majocchic purpura, Gougerot-Blum, Doucas-Kapetnakis, contact allergy)
Doesn't hug DEJ like a true lichenoid process
- grossly has cayenne pepper-like appearance, no petechia / purpura
Micro: Perivascular lymph infiltrate (akka lymphocytiv vasculitis), RBC extravasation, hemosiderin,
Rosacea
- aka acne rosacea
Long-term skin condition that typically affects the face, causing redness, pimples, swelling and small and superficial dilated BVs
- cause unknown, inc risk c pos fam hx, several exacerbating factors
- may affect up to 10% of population, usually whites bwt 30-50 yo
- M=F, though males tend to present later
May see inc numbers of Demodex mites, and pts have been reported to have inc antimicrobial peptide cathelicidin
4 subtypes (can have multiple subtypes):
1. Erythematotelangiectatic rosacea shows permanent redness and tendency to blush easily, with telangiectatic vessels and possibly burning or itching, skin can be dry or flaky
2. Papulopustular rosacea presents c permanent redness with red papules and can be confused with acne
3. Phymatous rosacea is MC assoc c rhinophyma (an enlarged nose with surface irregularities)
4. ocular rosacea, affects eyes and eyelids which appear red and can be sensitive to light
Micro: broad spectrum of histopathologic changes seen
- may see prominently dilated BVs, usually mild to mod perivascular lymph infiltrate, a few plasma cells, and can have an active component
- rhinophyma usually shows sebaceous gland hypertrophy with scattered follicular plugging
- granulomatous form can have tuberculoid reaction usually around damaged hair follicles and necrosis with caseation
Tx: avoid triggers, several meds can help (ivermectin, isoretinoin)
Bullous Ichthyosis
- aka bullous congenital ichthyosiform erythroderma
AD, defective KRT1 or KRT10 genes
Micro: epidermolytic hyperkeratosis
- can be seen in b9 epidermal tumors or incidental finding

Bullous Ichthyosis

Infectious Dermatology
Arthropods
Scabies
May see mites, their eggs, or scabyla ?? in upper epidermis; "pigtails" in corneum (mite's egg fragments
- also chitinous substance
- inflam response similar to most other insect bites, pretty itchy
- possible skin separation c eos response, resembling bullous pemphigoid or Langerhans cell histiocytosis
Bacteriae
Bacillary angiomatosis
Bright red firm friable exophytic (big and bulging) papules caused by BArtonellA in AIDS pts that can be mistaken for Kaposi sarcoma
- usually not distinctly lobular; deep clusters of neutros in lesion; amphophilic collections of organisms
IHC: Bartonella organisms stain with Warthin-Starry or Giemsa stains
Tx: erythromycin
Granuloma inguinale
Bacterial dz cuase by Klebsiella granulomatis causing ulcerative genital lesions
Micro: PEH with abscesses of neutros
Donovan bodies - bacteria seen in cytoplasm of histiocytes seen best on thin sections
Leprosy
Micro: Globi (clear balls c central pink collection of mycobacteria inside that are highlighted by Fite)
- sheets of histiocytes around vessels and also grenz zone
IHC: Fite stain
Rhinoscleroma
Dz caused by Klebsiella rhinoscleromatis that has ctarrhal / atrophic, granulomatous, and sclerotic stages
- manifests as nodules of URT that can cause permanent disfigurement
Histo: sheets of plasma cells c Russell bodies (pink pregnant plasma cells) and Mukulicz cells (histiocytes c large round collections of bacilli)
Viri
Condyloma acuminatum
Positive hybridization can be seen for HPV
Micro: B9 acanthoma on genital skin, c compact corneum, hyperkeratosis, coarse hypergranulosis, vacuolated keratinocytes (c large gray nuclei)
Condyloma latum
Moist white papules in genital region 2/2 secondary syphilis
Histo: epidermal hyperplasia c lichenoid inflam c lots of plasma cells
IHC: can see Treponema pallidum c Wathin-Starry
Cytomegalovirus
Epidermodysplasia Verruciformis (EDV)
Genetic disposition to HPV-3/5/8/10 due to mutations in EVER1 and EVER2 genes making warts more persistent and widespread than normal
Widespread flat warts c cells that are large in granular and spinous layers foamy blue cytoplasm and clear nucleoplasm (perinuclear halo??)
Herpes simplex
the M's: Molding, Multinucleation, Mulberry-shaped, Margination
- leukocytoclastic vasculitis, just a little
Herpes Zoster
the M's: Molding, Multinucleation, Mulberry-shaped, Margination
- leukocytoclastic vasculitis pronounced
Molluscum contagiosum
Infection due to molluscum contagiosum pox virus which presents as multiple nodules on skin of trunk or anogenital regions 2/2 skin contact (possibly sexual)
Micro: look for molluscum bodies (aka Henderson-Patterson) which are large keratinocytes c cytoplasmic, light red grainy inclusions that push the nucleus to the side
- dense infiltrate of lymphocytes may lead to thinking of lymphoma
Varicella
Similar to herpes simplex
Viral exanthem
Clinically looks like a generalized eruption or morbiliform (measels-like) rash
- show light superficial perivasc lymph infiltrate
- skin almost appears normal
Verruca plana
The flat wart, caused by HPV-3 or -10
Micro: "Bird's eye" cells that look like koilocytes without a shriveled up nucleus, which are perinuclear halos with condensation of keratohyaline granules
- hypergranulosis with vacuolization, acanthosis and basket-weave hyperkeratosis
Verruca vulgaris
The common wart
Micro: Compact corneum c papillomatosis that curves in towards the middle
- koilocytes may be seen
Warty Dyskeratoma (WD)
Presents as umbilicated papule c keratotic plug, usually on the head, neck or face
- solitary and sporadic
Micro: central cystic space with radiating pseudovilli made by acantholytic dyskeratosis
Genes: lack SERCA2, suggestive of an acquired genetic mutation in ATP2A2
Fungi / Yeast
Chromoblastomycosis
Chronic deep skin fungal infx affecting the traumatic innoculation site
- causative agent include several fungi in soil, wood and decaying plant material
- Phialophora verrucosa
Fonsecaea pedrosi (most common pathogen, accounts for > 90% of the cases in South America)
Fonsecaea compacta
Cladosporium carrionii
Rhinocladiella aquaspersa (Ramichloridium cerophilum)
Usually in tropical / subtropical areas, such as Brazil, Mexico, Colombia, Cuba, Dominican Republic
- esp seen in barefoot farmers and men
- presentation is usually verrucous lesion in extremities of adult men in outdoor work
- slowly progressive, usually ~15 years from initial lesion to time of dx
- may have elephantiasis
Micro: sclerotic bodies with pseudoepitheliomatous hyperplasia c intraepidermal abscess and pigmented fungal sclerotic boddies (Mediar bodies or copper penny bodies)
Dx: Culture at 25-30 C grows olive-green to black fungal colonies after 1-2 weeks
Tx: difficult and long, 1/3 cure rate, 2/3 improve, 1/10 fail tx
Tinea nigra
MC in hot and humid climates, infection by Hortaea werneckii that occurs on the palm and soles
- can see the pigmented hyphae in the corneum, but does not have melanocytic atypia
- can look similar to acral lentiginous melanoma (as a brown patch on the palms and soles)
Tinea versicolor
Tan, slightly scaly patches on trunk and extremities that can look similar to flat warts
Micro: loose basket-woven hyperkeratosis
- "Ziti and meatballs" groups of round spores and short curved hyphae in stratum corneum
IHC: can highlight hyphae and spores c PAS
Protothecosis
Very rare; Algal infection; aerobic, achlorophyllous, algae-like, unicellular organisms in water, sewage and soil
- may infect toenails of pts c diabetes
- primary cell or spherule is the theca; reproduce by internal septation forming sporangia with up to 20 endospores
- can be P wickerhamii or P zopfii
Micro: necrotizing granuloma of subcutis c spherical organisms c central basophilia, internal septation and double layer walls
IHC: (+) PAS
Tx: Amphoteracin in disseminated, surgery if local
Erythasma
Intertriginous rash distribution 2/2 Corynebacteria (gram+ filamentous rods) with characteristic orientation in stratum corneum
Micro: vertically oriented filamentous bacteria in parakeratottic stratum corneum

Molluscum contagiosum


Herpes
Protothecosis

Chromoblastomycosis with copper penny bodies

WD with central white keratin core
WD


Verruca vulgaris


Verruca vulgaris - Prominent granular layer (red), hyperkeratosis (blue) papillomatous hyperplasia (green), inward bending of rete (yellow)

Verruca plana

Verruca plana



Condlyoma acuminatum
Diagram of condyloma acuminatum


Condyloma latum



EDV
EDV
EDV
<
>

Malassezia furfur

Erythasma
Chromoblastomycosis

Lobomycosis, seen in the pink river dolphin

Lepromatous leprosy



WD`
Genodermatosis, metabolic and other structual disorders
Chondrodermatitis nodularis chronica helicis
Small, single painful crusty papule on ear helix in men >40 yo that may be mis diagnosed as epithelial neoplasm
- usually hx of ear trauma (seen in telephonists and nuns that wore a wimple)
Histo
Ulceration, chronic inflam c hyper- and parakeratosis surrounding ulcer
- base of ulcer c granulation tissue involving cartilage usually
- may look like a glomus tumor 2/2 vascular prolif
Ulcer c adjacent acanthosis over layer of fibrin, which is surrounded on both sides by granulation tissue and ectatic vessels
- may see cartilage underneath depending on depth of biopsy
Mastocytosis / Urticaria Pigmentosa (UP)
UP is sporadic (not inherited) dz c multiple tan macules or patches
- UP is MC in childhood, but when involved in adults assoc c systemic dz and marrow involvement
Darier's sign - urtication (wheal and flare) c stroking
Micro: fried-egg mast cells in a reticular polka dot pattern in the upper 1/3 of the dermis
- small inc in spindly perivascular mast cells in telangiectasia musclaris eruptiva perstans (TMEP)
Genes: c-kit mutations seen in sporadic but not typical pediatric UP
IHC: (+) Giemsa used to identify granules in mast cells, c-kit stains similarly, (+) CD117
- neg: S100, CD1a, CD68, MelanA
- normal melanocytes and melanocytic lesions will also express CD117
Malignant Atrophic Papulosis
Intimal prolif of deep-seated arterioles that cause infarcts
- Dego's disease - variant causing a lethal syndrome, involving small bowel, heart, lungs, kidney, bladder and liver
- also benign and familiar variants
Clinically see small patches with central zone c depressed white, procelain like appearance and fine scale surrounded by narrow red or violaceous rim c fine telangiectasia
- skin lesions usually in trunk and prox extremity
Micro: hyperkeratotic and atrophic epidermis
- wedge-shaped dermal infarct c base parallel to surface epithelium
- pale and relatively acellular
- older lesions ulcerated
- endovasculitis in dermal vessels c endothelial cell hyperplasia and complicated by thrombosis
Pseudoxanthoma elasticum (PXE)
Rare, AR inherited metabolic dz of CT, though in 2% may be AD; first described in 1881 by Rigal
- characterized by mineralization of CT (elastic fibers), c primary clinical manifestations in skin, eyes, GI (causes GI bleeding), and CV system
- dx based on cutaneous and ocular signs, histopathology and pts fam hx
Skin lesions are yellowish asymptmatic papules, symmetric in neck and flexural areas (esp axilla)
- Ocular changes are angioid streak seen on ophthalmoscopy
- CV changes are calcification of small and med sized arteries, causing early atheromatosis, HTN, AMI
Micro: fragmented / distorted elastic fibers in reticular and deep dermis, which can be highlighted c Verhoeff-Van Gieson (VVG) stain, and Von Kossa (Ca2+) stains
- sometimes called purple Cheetos
Genes: ABCC6 / MRP6 gene, causing reduction or absence of transmembrane transport ADP dependent protein (MRP6) causing accumulation of extracellular material c subsequent deposition of Ca2+ and other minerals in elastic tissue
Px: may cause sudden death from coronary atherosclerosis c AMI, HTN, MVP, GI bleeds, or cerebral ischemia


Chondrodermatitis nodularis chronica helicis
Mastocytosis

Dego disease

Pseudoxanthoma elasticum

References
1. UpToDate. Lymphomatoid Papulosis
